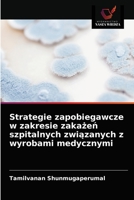
Strategie zapobiegawcze w zakresie zakażeń szpitalnych związanych z wyrobami medycznymi 6202874155 Book Cover
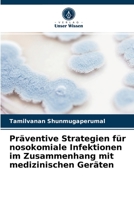
Präventive Strategien für nosokomiale Infektionen im Zusammenhang mit medizinischen Geräten 6202874120 Book Cover
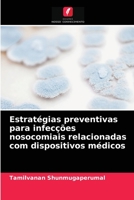
Estratégias preventivas para infecções nosocomiais relacionadas com dispositivos médicos 6202874090 Book Cover
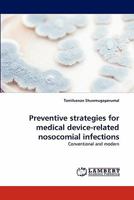
Preventive Strategies for Medical Device-Related Nosocomial Infections 3844301844 Book Cover
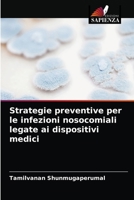
Strategie preventive per le infezioni nosocomiali legate ai dispositivi medici 6202874139 Book Cover
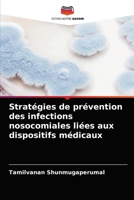
Stratégies de prévention des infections nosocomiales liées aux dispositifs médicaux 6202874112 Book Cover

- Biofilm Eradication and Prevention: A Pharmaceutical Approach to Medical Device Infections
- Oil-in-Water Nanosized Emulsions for Drug Delivery and Targeting
- Clinical concerns of immunogenicity produced by biopharmaceuticals: Mechanism, prediction and reduction
- Excipients used in the design of lipidic and polymeric microspheres: An interim update
- Survey of active pharmaceutical ingredients-excipient incompatibility
Tamilvanan Shunmugaperumal
Books by Tamilvanan Shunmugaperumal

Biofilm Eradication and Prevention: A Pharmaceutical Approach to Medical Device Infections
$184.61

Oil-in-Water Nanosized Emulsions for Drug Delivery and Targeting
$232.34
Strategie zapobiegawcze w zakresie zakażeń szpitalnych związanych z wyrobami medycznymi
Out of Stock

Clinical concerns of immunogenicity produced by biopharmaceuticals: Mechanism, prediction and reduction
Out of Stock

Excipients used in the design of lipidic and polymeric microspheres: An interim update
Out of Stock

Microparticulate Dosage Form for Non-Steroidal Anti-Inflammatory Drugs
Out of Stock
Präventive Strategien für nosokomiale Infektionen im Zusammenhang mit medizinischen Geräten
Out of Stock
Estratégias preventivas para infecções nosocomiais relacionadas com dispositivos médicos
Out of Stock
Preventive Strategies for Medical Device-Related Nosocomial Infections
Out of Stock
Strategie preventive per le infezioni nosocomiali legate ai dispositivi medici
Out of Stock
Stratégies de prévention des infections nosocomiales liées aux dispositifs médicaux
Out of Stock

Survey of active pharmaceutical ingredients-excipient incompatibility
Out of Stock



